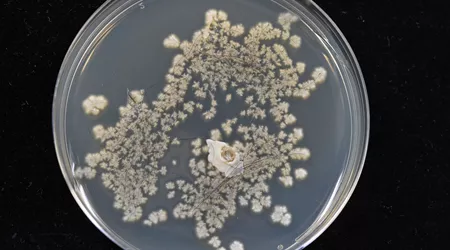

Det skal gå minst 48 timer før du har kontakt med klauvdyr i Norge dersom du har vært utenlands. Dersom du er i kontakt med klovdyr eller fjørfe i land med alvorlige smittsomme sykdommer, bør du vente minst 72 timer før du har kontakt med klovdyr eller fjørfe i Norge.
Vær derfor oppmerksom på at det nå er 72 timer karenstid dersom du har vært i Tyskland.
I Geno er vi ekstra oppmerksomme på utbruddet av munn- og klauvsjuke i Tyskland og har ekstra strenge forhåndsregler for besøk på våre anlegg.
Les mer om smitteutbruddet og råd om smittevern her:
Animalia
Veterinærinstituttet
Mattilsynet